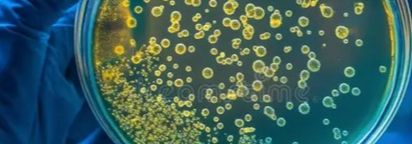

Discover more
Discover in this video by Innosuisse the project idea “Food Basket for Social Impact” and how its team members could benefit from participating to an Innovation Booster. The project idea was created at and supported by our previous Innovation Booster Swiss Food Ecosystem (2021-2024).